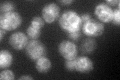
YJL097W
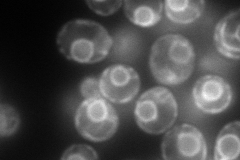
YJL097W
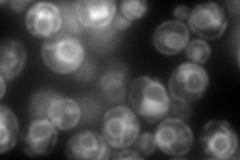
YJL097W
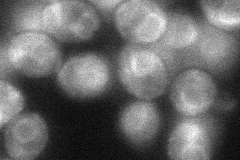
YJL097W
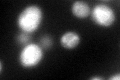
YJL097W

View description
Essential 3-hydroxyacyl-CoA dehydratase of the ER membrane, involved in elongation of very long-chain fatty acids; evolutionarily conserved, similar to mammalian PTPLA and PTPLB; involved in sphingolipid biosynthesis and protein trafficking
Localization:
Intensity:
Fold change:
Significance:
-
C’ GFP library in SD
ER53.3 -
N' NOP1pr-GFP in SD
ER183.84 -
N' TEF2pr-mCherry in SD
ER318.037 -
N' NATIVEpr-GFP in SD

ER55.951 -
N' TEF2pr-VC and Cyto-VN in SD
ER47.48 -
C’ GFP library in SD+DTT
ER63.351.18No -
C’ GFP library in SD+H2O2

ER44.350.83No -
C’ GFP library in Starvation Media

ER36.990.69No -
C’ GFP library on the background of Pup2-DaMP

N/A -
C’ GFP library on the background of CCT mutant

N/A0N/AYes
